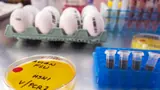
Recommended image2

Bird Flu Panic! Can't Eat Chicken? See a Doctor for These Symptoms!
bird flu: After a dead crow in Chennai tested positive for bird flu, a review meeting was held, led by the Chief Secretary, to prevent its spread.

Bird Flu
In Tamil Nadu, crows were reported dead in some districts, especially in parts of Chennai. Bird flu was found in one dead crow. A review meeting for all department officials was held at the Secretariat, led by the Chief Secretary, to speed up prevention measures.

Consultation regarding bird flu
Top officials from Health, Municipal Admin, Animal Husbandry, Chennai Corp, Forest, and other related departments attended the meeting to discuss bird flu control measures.
Precautionary measures
The Director of Public Health explained how bird flu spreads and confirmed no human cases in the state yet. He detailed the precautions taken. Guidelines to prevent human transmission have been sent to all departments.
Important instructions for the public
Key advice: Don't panic. Report dead birds to authorities. See a doctor for fever or breathing issues. Cook chicken and eggs well. Ignore rumors. Call 104 for info.
Stay updated with the Breaking News Today and Latest News from across India and around the world. Get real-time updates, in-depth analysis, and comprehensive coverage of India News, World News, Indian Defence News, Kerala News, and Karnataka News. From politics to current affairs, follow every major story as it unfolds. Get real-time updates from IMDon major cities weather forecasts, including Rain alerts, Cyclonewarnings, and temperature trends. Download the Asianet News Official App from the Android Play Store and iPhone App Store for accurate and timely news updates anytime, anywhere.